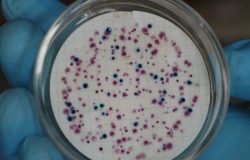

Kathmandu : Every morning, children can be seen playing in the alleys and neighborhoods of our cities. But the environment in which they play is not the same everywhere. Some streets have open drains, some are piled with garbage, and many families still lack access to safe toilets. In such a situation, the idea of ...
English
-
-
Why Should a Child’s Feces Always Be Disposed of in a Toilet?
Kathmandu : Many parents may think that a child’s feces is small and therefore not very harmful. But experts say, “A child’s feces is just as dangerous as that of an adult.” When thrown in the open or with household waste, it poses serious health risks to both families and communities. Health Protection Ch...
-
Technical Fault Found at Tikapur Fecal Sludge Treatment Plant (With Video)
Kailali: A technical fault has been identified at the fecal sludge treatment plant built in Tikapur, Kailali. The issue was discovered after the construction company operated the facility for two years and then handed it over to the municipality. The problem lies in the plant’s screening chamber, which is set hi...
-
Human Waste Management: A Path to Public Health and Clean Living
Kathmandu : One day in Hanumandhoka, Kathmandu, tourists were exploring the historic sites. Suddenly, a foul smell spread from an old sewer nearby. A local remarked, “This stench is the reality of our city.It happens quite often.” That smell in the city was from human waste. We often treat the subject of human e...
-
Trust in the Board During Crisis: No Drinking Water Shortage Even Amid Drought
Sarlahi: Due to prolonged drought in the Terai-Madhesh region, residents of Malangwa, the district headquarters of Sarlahi, and Bramhapuri Rural Municipality faced severe drinking water shortages, leaving them desperate for water. As the underground water level dropped and handpumps stopped functioning, locals were...
-
Birgunj Cholera Outbreak Highlights Critical Need for Safe Sanitation to Protect Public Health
Kathmandu : More than a week after the cholera outbreak began in Birgunj, the situation is still not under control. Currently, nearly 200 people have been infected in Parsa district. In Birgunj and Pokhariya, the total number of cases has reached 193. According to data released by the Birgunj Metropolitan City Offic...
-
Sanitation Gap in Nepal: Two Out of Every Five Lack Safe Sanitation, Says WHO–UNICEF
Kathmandu: The World Health Organization (WHO) and the United Nations Children’s Fund (UNICEF) have released a new report revealing that two out of every five people in Nepal still do not have access to safely managed sanitation services. The report, titled “Progress on Household Drinking Water and Sanitation 2000–2...
-
Agenda for Change Nepal Develops Three-Year Roadmap
Lalitpur: Agenda for Change Nepal has developed a roadmap for the coming three years (2025–2028). The roadmap was prepared with the participation of member organizations of the Agenda for Change Nepal Chapter as well as government officials, outlining the way forward until 2028. According to Seema Rajouria, Lead of ...
-
Dangerous microbes found in tap water in Kathmandu
The Public Health Office, Kathmandu, has urged the public to boil water before drinking, after tests showed the presence of hazardous microbes in samples of drinking water. Officials say that water samples collected from Chandragiri, Nagarjun and Tokha municipalities on the fringes of Kathmandu Valley were found...
-
Importance of Legal Instruments for Safe Sanitation
Safely managed sanitation is directly linked to public health, environmental protection, and social dignity. Unsafe disposal of human excreta contaminates water sources, spreads diseases, disrupts environmental balance, and undermines human rights. To address these challenges, legal instruments have been established ...
- « Previous Page
- 1
- …
- 6
- 7
- 8
- 9
- 10
- …
- 55
- Next Page »